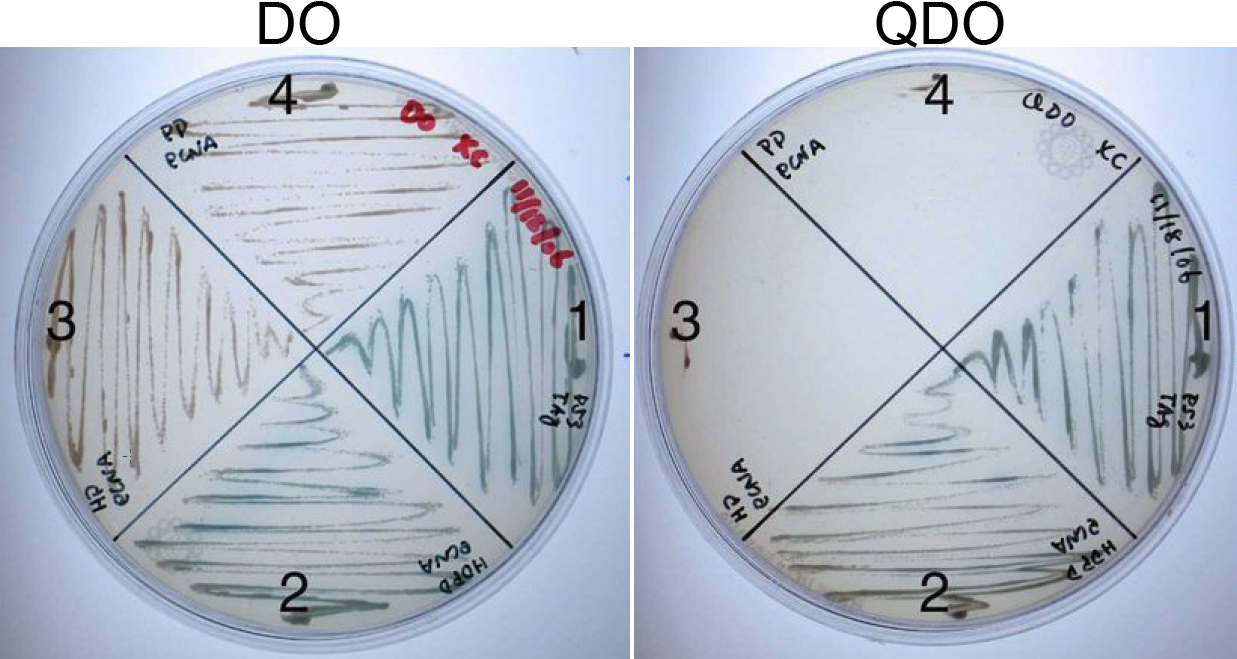

Figure 1. PCNA interacts with the integrated homeo-Prospero domain (HDPD) of Prox1 but not the homeodomain (HD) or Prospero domain (PD)
alone. Yeast strain AH109 transformed with vectors expressing fusions of the DNA binding domain of GAL4 and the HDPD, HD,
and PD, respectively, were mated with yeast strain Y187 transformed with a vector expressing the activation domain of GAL4
fused to the carboxyl-terminus of PCNA (original clone isolated from the library) and plated on double drop out (DO) media
to select for the presence of both plasmids. Colonies from these plates were restreaked on either DO (to demonstrate presence
of all vectors in the yeast) or quadruple drop out (QDO) plates to test for interaction between the protein products. (1)
The known interaction between P53-SV40 T antigen was used as a positive control. (2) Yeast resulting from the mating between
the HDPD bait plasmid and the PCNA prey plasmid grew on QDO plates and expressed the α-galactosidase reporter (blue colonies).
(3) Yeast containing both the Prox1 HD and the C-terminus of PCNA did not grow under QDO selection. (4) Yeast containing
both the Prox1 PD and the C-terminus of PCNA did not grow under QDO selection.